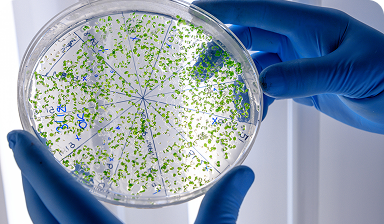

Precision
Testing for
Excellence
& Safety
Leading analytical laboratory services for food and pharmaceutical industries. Over two decades of expertise ensuring quality, safety, and regulatory compliance with cutting-edge technology and certified methodologies.
25+
Years Experience
10,000+
Tests Annually
99.9%
Accuracy Rate
24/7
Support Available
Our Expertise
Comprehensive Testing Services
From microbiology to nutritional labeling, we provide full-spectrum laboratory
solutions backed by decades of experience
solutions backed by decades of experience

Chemistry Analysis
Comprehensive analytical chemistry solutions for all your testing needs.
- Food residue analysis
- Pesticide analysis
Microbiology
Industry-leading microbiological testing services with state-of-the-art facilities.
- Pathogen Testing
- Environmental Monitoring
- Shelf Life Studies

Quality Systems
ISO-certified quality assurance and control programs.
- ISO certification in progress
- Centralized LIMS (laboratory…)
- Consulting Services

Instrumentation
Advanced testing equipment for precise analytical results.
- LC-MS/MS Analysis
- HPLC Analysis
- GC Analysis
- RT-PCR

Nutritional Labeling
Complete nutritional analysis for federally mandated labeling requirements.
- Nutrition Facts Panel
- Proximate Analysis
- Label Verification
- Compliance Review
FDA Import Alert
FDA recognized for automatic detention program compliance.
- Import Compliance
- Regulatory Testing
- Rapid Turnaround
How It Works
Simple, Streamlined Process
From sample submission to results delivery, we’ve made it easy
01
Sample Submission
Send samples via courier or drop-off
02
Laboratory Testing
Advanced analysis by certified technicians
03
Quality Review
Comprehensive validation and verification
04
Results Delivery
Detailed reports via secure portal
About Us
Two Decades of Scientific Excellence
Vega Analytical Labs has been at the forefront of analytical testing services. Our commitment to scientific excellence, regulatory compliance, and customer service has made us a trusted partner for companies worldwide.
We combine state-of-the-art equipment with industry-leading expertise to deliver accurate, reliable results that you can trust for critical business decisions.
Testimonials
What Our Clients Say
Jennifer Martinez
Quality Director, Global Foods Inc.
"Vega Analytical Labs has been our trusted partner for over 5 years. Their accuracy and turnaround times are exceptional."
Jennifer Martinez
Quality Director, Global Foods Inc.
"Vega Analytical Labs has been our trusted partner for over 5 years. Their accuracy and turnaround times are exceptional."
Jennifer Martinez
Quality Director, Global Foods Inc.
"Vega Analytical Labs has been our trusted partner for over 5 years. Their accuracy and turnaround times are exceptional."
Ready to Get Started?
Partner with Vega Analytical Labs for reliable, accurate, and timely
testing services. Contact us today for a consultation.
testing services. Contact us today for a consultation.